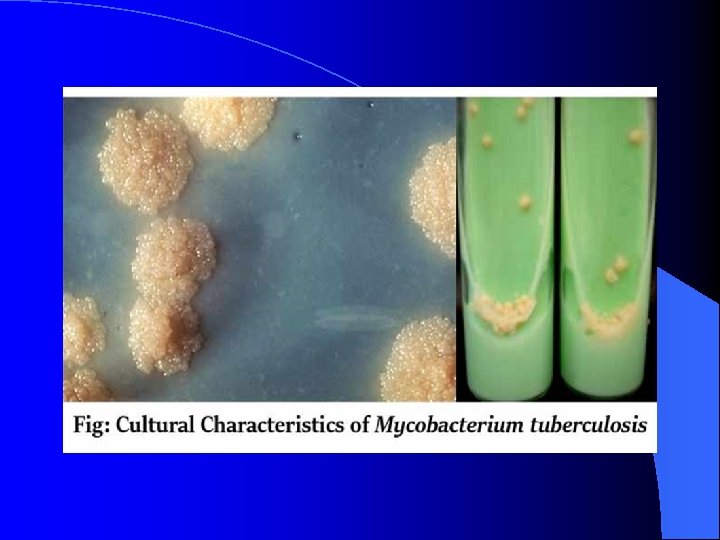

4c098b83f79a421b17caa404cfc618e6.ppt
- Количество слайдов: 34

TUBERCULOSIS Respiratory Block PROF. HANAN HABIB DEPRTMENT OF PATHOLOGY, MICROBIOLOGY UNIT KSU

Objectives l Recognize that tuberculosis as a chronic disease mainly affecting the respiratory system. l Know the epidemiology of tuberculosis world wide and in the kingdom of Saudi Arabia l Understand the methods of transmission of tuberculosis and the people at risk.

l Know the causative agents , their characteristic and staining methods. l Understand the pathogenesis of tuberculosis. l Differentiate between primary and secondary tuberculosis and the clinical features of each.

l Understand the method of tuberculin skin test and result interpretation. . l Know the laboratory diagnostic methods. l Know the chemotherapeutic agents and other methods of management. l Describe the methods of prevention and control of tuberculosis. l

Introduction l Tuberculosis (TB) is an ancient , chronic disease affects humans, caused by Mycobacterium tuberculosis complex. l A major cause of death worldwide. l Usually affects the lungs, other organs can be affected in one third of cases. l If properly treated is curable, but fatal if untreated in most cases.

Epidemiology Ø TB affects 1/3 of human race ( 2 billions) as a latent dormant tuberculosis. Ø Incidence: a world wide disease , more common in developing countries. Ø Affects all age groups who are subject to get the infection.

Epidemiology l The WHO estimated 8. 9 million new cases in 2004 & 2 - 4 million death. l Incidence in KSA ( 2011 Data): 0 -24 cases /100, 000 population see diagram for other countries.


Transmission Ø Transmission mainly through inhalation of airborne droplet nuclei ( < 5 μm) in pulmonary diseases case , rarely through GIT & abraded skin Ø Reservoir: patients with open TB. Ø Age: young children & adults Ø People at risk : lab. technicians, workers in mines, doctors , nurses. HIV, diabetics end stage renal failure, contacts with index case.

Characteristics of the Genus Mycobacteria Ø Slim, rod shaped, non-motile, do not form spores. Ø Do not stain by Gram stain. Why ? Ø Cell wall contains high conc. of Mycolic acid and other lipids which resist Gram staining. Ø Stained by Zieh-Neelsen ( Z-N ) and Auramine staining

l acid- alcohol fast as it resists decolorization with up to 3% HCL, 5%ethanol or both l Mycobacterium species appear tiny red bacilli acid fast bacilli ( AFB) by Z-N stain


Z-N stained smear showing AFB

Mycobacteria Ø Strict aerobe Ø Intracellular multiplication Ø Slowly growing ( 2 - 8 wks. )

Mycobacterium tuberculosis complex Ø 1 - M. tuberculosis (Human type) Ø 2 - M. bovis (Bovine type) Ø 3 - M. Africanum Ø 4 - BCG strains All can cause TB.

Pathogenesis of Tuberculosis l Mycobacteria acquired by airborne droplet reaches the alveolar macrophages , survive their ( main virulence factor). l This starts cell mediated immune response which controls the multiplication of the organism but does not kill it. l Granuloma formed , organism lives in dormant state ( latent tuberculosis infection)

Pathogenesis of Tuberculosis l Patient show evidence of delayed cell mediated immunity ( CMI ). l Disease results due to destructive effect of CMI. l Disease develop slowly and chronic l Clinically the disease is divided into primary or secondary.

Pathogenesis of Tuberculosis Ø Primary Tuberculosis Occurs in patients not previously infected. Inhalation of bacilli Phagocytosis lymph nodes calcify to produce GHON focus (or Primary Complex) at the periphery of mid zone of lung. Infection handled by host response. In some people disseminate or remain viable for long period


Primary Tuberculosis Ø Microscopy of lesion shows Granuloma. Ø Clinically: primary TB usually asymptomatic or / minor illness. Ø Non-pulmonary TB: may spreads from pulmonary infections to other organs eg. : § TB of lymph nodes ( cervical, mesenteric). § TB meningitis § TB bone & joint

Primary Tuberculosis Ø Genitourinary TB Ø Miliary TB (blood and other organs) Ø Soft tissue (cold abscess): lack of inflammation with caseation. Ø Caseation: due to delayed hypersensitivity reaction. Contains many bacilli , enzymes, O 2, N 2 intermediates, necrotic center of granuloma with cheezy material.

Secondary TB (reactivation) Ø Occurs sometime at lifetime Ø Lung more common site Ø Immunocompromised patients. Ø Lesion localized in apices Ø Infectious & symptomatic Ø Microscopy: many bacilli, large area of caseous necrosis cavity (open TB) with granuloma and caseation.

Secondary TB Ø Clinically: fever, cough, hemoptysis , weight loss & weakness. Ø Source of secondary TB : - Endogenous (reactivation of an old TB) or - Exogenous (re-infection in a previously sensitized patient who has previous infection with the organism). - Secondary TB may be localized or spread to other organs

Laboratory Diagnosis of TB Ø 1 - Specimens: § Pulmonary TB: three early morning sputum samples ( or induced cough), or bronchial lavage, or gastric washing (infants) in 3 consecutive days. Ø Cerebrospinal fluid ( CSF) ( TB meningitis) Ø 3 early morning urine Ø Bone , joint aspirate Ø Lymph nodes, pus or tissues NOT Ø Repeat sample. swab.

Laboratory Diagnosis of TB Ø 2 - Direct microscopy of specimen : § Z-N or (Auramine ) stain. Ø 3 - Culture: the gold standard test for identification and sensitivity. § Media used: Lowenstein-Jensen media (L J). Media contains: eggs, asparagin, glycerol, pyruvate/ malachite green.

Lab detection of Mycobacteria Colonies appear in LJ media after 2 -8 weeks as eugenic, raised, buff, adherent growth enhanced by glycerol (MTB) or by pyruvate (M. bovis). Ø Other media plus LJ media may be used ( fluid media). Ø o o MGIT ( mycobacteria growth indicator test ) Automated methods : - eg. Bactec MGIT. Interferon –gamma release assay: positive in latent TB. Molecular method : eg. Prob. Tech ; detects nucleic acid directly from respiratory samples. Xpert MTB/RIF detect nucleic acid and resistance to rifampicin.

Identification Ø Morphology , growth at 37 C + 5 -10 % CO 2 Ø Biochemical tests : Niacin production & Nitrate test. o Sensitivity testing to detect susceptibility / resistance to ant-TB drugs

Management of a TB case Ø Isolation for 10 -14 days ( for smear positive cases i. e. > 1000 organisms / ml of sputum considered infectious case ). Ø Triple regimen of therapy. Why ? § To prevent resistant mutants § To cover strains located at different sites § To prevent relapse Ø Treatment must be guided by sensitivity testing.

First Line Treatment Ø Ø Ø o Ø Isoniazid ( INH) Rifampicin ( RIF) Ethmbutol ( E) Pyrazinamide (P) Streptomycin (S) INH+ RIF + P (or E) + S for 2 months then continue with INH+RIF for 4 -6 months. Multidrug resistant TB is resistance to INH & RIF. Directly Observed Therapy (DOT) required.

Second Line Used if the bacteria was resistant to first line drugs. More toxic than the first line drugs. Ø PASA ( Para-Amino Salicylic acid) Ø Ethionamide Ø Cycloserine, Ø Kanamycin, Ø Fluroquiolones

Tuberculosis: (a) Chest X-ray of a patient with tuberculosis bronchopneumonia. (b) Chest X-ray of the same patient 10 months after antituberculous therapy. (Courtesy of Dr. R. S. Kennedy)

Prevention of TB Ø Tuberculin testing of herds. Ø Slaughter of infected animals. Ø Pasteurization of milk to prevent bovine TB Ø Recognition of new cases. Ø Prophylaxis with INH of contacts. Ø Follow up cases. Ø Immunization with BCG to all new borne.
4c098b83f79a421b17caa404cfc618e6.ppt